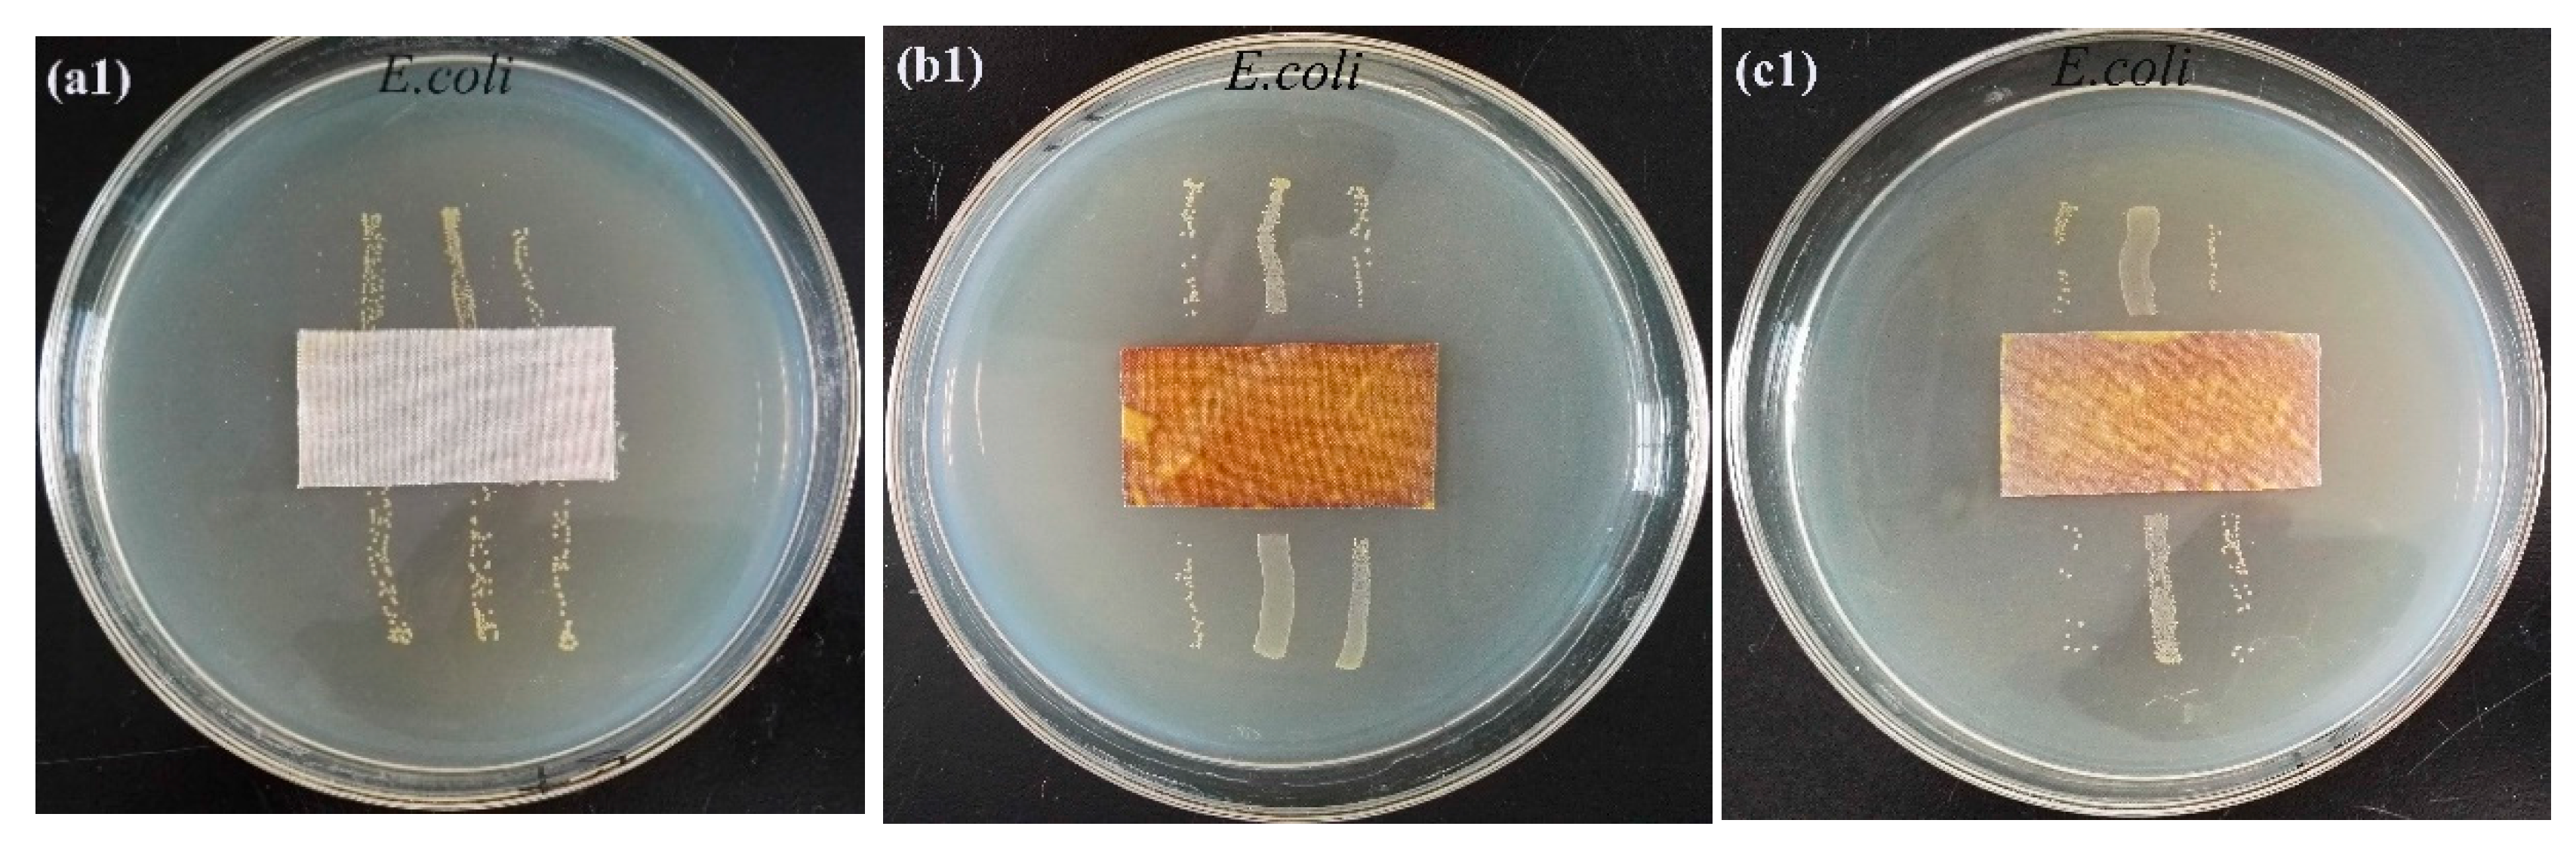
Materials 15 02537 g006a

In Situ Synthesis of Silver Nanoparticles on Flame-Retardant Cotton Textiles Treated with Biological Phytic Acid and Antibacterial Activity
Abstract
1. Introduction
2. Experimental
2.1. Materials
2.2. Flame-Retardant Finishing
2.3. Flame-Retardant Antibacterial Finishing
2.4. Characterization
2.5. Assessment of Cotton Fabrics
3. Results and Discussion
3.1. Mechanism of In Situ Reduction
3.2. XRD Analysis
3.3. SEM and TEM Analyses
3.4. XPS Analysis
3.5. LOI Analysis
3.6. Homogeneity Analysis
3.7. Antibacterial Properties
3.8. Thermal Performances
4. Conclusions
Author Contributions
Funding
Institutional Review Board Statement
Informed Consent Statement
Data Availability Statement
Conflicts of Interest
References
- Andra, S.; Balu, S.K.; Jeevanandam, J.; Muthalagu, M.; Michael, K. Surface cationization of cellulose to enhance durable antibacterial finish in phytosynthesized silver nanoparticle treated cotton fabric. Cellulose 2021, 28, 5895–5910. [Google Scholar] [CrossRef]
- Herfst, S.; Böhringer, M.; Karo, B.; Lawrence, P.; Lewis, N.S.; Mina, M.J.; Russell, C.J.; Steel, J.; Swart, R.L.; Menge, C. Drivers of airborne human-to-human pathogen transmission. Curr. Opin. Virol. 2017, 22, 22–29. [Google Scholar] [CrossRef] [PubMed]
- El-Shishtawy, R.M.; Asiri, A.M.; Abdelwahed, N.A.M.; Al-Otaibi, M.M. In situ production of silver nanoparticle on cotton fabric and its antimicrobial evaluation. Cellulose 2011, 18, 75–82. [Google Scholar] [CrossRef]
- Shikawa, T.; Nakatsuru, Y.; Zarkovic, M.; Shamsuddin, A.M. Inhibition of skin cancer by IP6 in vivo: Initiation-promotion model. Anticancer Res. 1999, 19, 3749–3752. [Google Scholar]
- Tang, F.; Wang, X.Y.; Xu, X.J.; Li, L.D. Phytic acid doped nanoparticles for green anticorrosion coatings. Colloids Surf. A Physicochem. Eng. Aspects 2010, 369, 101–105. [Google Scholar] [CrossRef]
- Laufer, G.; Kirkland, C.; Morgan, A.B.; Grunlan, J.C. Intumescent multilayer nanocoating, made with renewable polyelectrolytes, for flame-retardant cotton. Biomacromolecules 2012, 13, 2843–2848. [Google Scholar] [CrossRef] [PubMed]
- Jie, X.; Mei, Y.P.; Chen, Z.L.; Sun, D.Q.; Chen, G.Q.; Guan, J.P. Technological condition and properties testing of flame—retardant silk fabrics prepared by electrostatic layer-by-layer self assembly procedure. Sci. Ser. 2014, 40, 75–80. [Google Scholar]
- Cheng, X.W.; Guan, J.P.; Tang, R.C.; Liu, K.Q. Phytic acid as a bio-based phosphorus flame retardant for poly (lactic acid) nonwoven fabric. J. Clean. Prod. 2016, 124, 114–119. [Google Scholar] [CrossRef]
- Cheng, X.W.; Guan, J.P.; Chen, G.Q.; Yang, X.H.; Tang, R.C. Adsorption and flame retardant properties of bio-based phytic acid on wool fabric. Polymers 2016, 8, 122. [Google Scholar] [CrossRef]
- Cheng, X.W.; Liang, C.X.; Guan, J.P.; Yang, X.H.; Tang, R.C. Flame retardant and hydrophobic properties of novel sol-gel derived phytic acid/silica hybrid organic-inorganic coatings for silk fabric. Appl. Surf. Sci. 2018, 427, 69–80. [Google Scholar] [CrossRef]
- Capek, I. Preparation of metal nanoparticles in water-in-oil (w/o) microemulsions. Adv. Colloid Interface Sci. 2004, 110, 49–74. [Google Scholar] [CrossRef] [PubMed]
- Sharma, V.K.; Yngard, R.A.; Lin, Y. Silver nanoparticles: Green synthesis and their antimicrobial activities. Adv. Colloid Interface Sci. 2009, 145, 83–96. [Google Scholar] [CrossRef] [PubMed]
- Vimala, K.; Sivudu, K.S.; Mohan, Y.M.; Sreedhar, B.; Raju, K.M. Controlled silver nanoparticles synthesis in semi-hydrogel networks of poly (acrylamide) and carbohydrates: A rational methodology for antibacterial application. Carbohydr. Polym. 2009, 75, 463–471. [Google Scholar] [CrossRef]
- Bell, N.S.; Dunphy, D.R.; Lambert, T.N.; Lu, P.; Boyle, T.J. In situ characterization of silver nanoparticle synthesis in maltodextrin supramolecular structures. Colloids Surf. B 2015, 138, 98–104. [Google Scholar] [CrossRef] [PubMed]
- Zheng, Y.; Zhu, Y.F.; Tian, G.Y.; Wang, A.Q. In situ generation of silver nanoparticles within crosslinked 3D guar gum networks for catalytic reduction. Int. J. Biol. Macromol. 2015, 73, 39–44. [Google Scholar] [CrossRef] [PubMed]
- Logeswari, P.; Silambarasan, S.; Abraham, J.J. Synthesis of silver nanoparticles using plants extract and analysis of their antimicrobial property. Saudi. Chem. Soc. 2015, 19, 311–317. [Google Scholar] [CrossRef]
- Zhou, Q.Q.; Lv, J.C.; Ren, Y.; Chen, J.Y.; Gao, D.W.; Lu, Z.Q.; Wang, C.X. A green in situ synthesis of silver nanoparticles on cotton fabrics using Aloe vera leaf extraction for durable ultraviolet protection and antibacterial activity. Text. Res. J. 2017, 87, 2407–2419. [Google Scholar] [CrossRef]
- Li, Z.R.; Meng, J.; Wang, W.; Wang, Z.Y.; Li, M.Y.; Chen, T.; Liu, C.J. The room temperature electron reduction for the preparation of silver nanoparticles on cotton with high antimicrobial activity. Carbohydr. Polym. 2017, 161, 270–276. [Google Scholar] [CrossRef] [PubMed]
- Zhu, P.F.; Wu, M.H.; Bao, J.Y. Nano-silver antibacterial finishing of methylacylamide grafted cotton fabric modified with maleic anhydride. Text. Aux. 2016, 1, 45–49. [Google Scholar]
- Zhang, E.F.; Wu, M.H.; Chen, J.; Liu, A.L.; Bao, J.Y. Nano-silver antibacterial finishing of cotton fabric grafted with methacrylamide. J. Text. Res. 2013, 4, 75–79. [Google Scholar]
- Zhang, D.S.; Chen, L.; Zhao, M. In-situ assembling of silver nanoparticles on modified active cotton fabric for antibacterial finishing. J. Text. Res. 2017, 38, 169–174. [Google Scholar]
- Lim, J.K.; Liu, T.; Jeong, J.; Shin, H.; Jin, S.P. In situ syntheses of silver nanoparticles inside silver citrate nanorods via catalytic nanoconfinement effect. Colloids Surf. A Physicochem. Eng. Aspects. 2020, 605, 125343–125351. [Google Scholar] [CrossRef]
- Feng, P.; Feng, X.B.; Xu, Y.P. Study on the complexation of phytic acid with metal ions. China Oils Fats 2006, 31, 63–66. [Google Scholar]
- Kavitha, M.; Parida, M.R.; Prasad, E.; Vijayan, C.; Deshmukh, P.C. Generation of Ag nanoparticles by PAMAM dendrimers and their size dependence on the aggregation behavior of dendrimers. Macromol. Chem. Phys. 2009, 210, 1310–1318. [Google Scholar] [CrossRef]
- Kéki, S.; János, T.; Deák, G.; Daróczi, L.; Zsuga, M.J. Silver nanoparticles by PAMAM-assisted photochemical reduction of Ag+. Colloid Interface Sci. 2000, 229, 550–553. [Google Scholar] [CrossRef] [PubMed]
- Tania, I.S.; Ali, M.; Azam, M.S. Mussel-inspired deposition of Ag nanoparticles on dopamine-modified cotton fabric and analysis of its functional, mechanical and dyeing properties. J. Inorg. Organomet. Polym. Mater. 2021, 31, 4065–4076. [Google Scholar] [CrossRef]
- Theivasanthi, T.; Alagar, M.J. Electrolytic synthesis and characterizations of silver nanopowder. Alloys Compd. 2011, 491, 499–502. [Google Scholar] [CrossRef]
- Chen, Q.Y.; Xiao, S.L.; Shi, S.Q.; Cai, L.P. A one-pot synthesis and characterization of antibacterial silver nanoparticle–cellulose film. Polymers 2020, 12, 440. [Google Scholar] [CrossRef]
- Tania, I.S.; Ali, M.; Azam, M.S. In-situ synthesis and characterization of silver nanoparticle decorated cotton knitted fabric for antibacterial activity and improved dyeing performance. Appl. Sci. 2019, 1, 64–73. [Google Scholar] [CrossRef]
- Xing, H.L.; Gao, S.T.; Xu, G.C.; Zhao, J.F.; Dou, N.; Bei, T.T.; Hong, G. Synthesis and characterization of nanosilver/PAAEM composites via emulsifier—free emulsion polymerization ultrasonically. Chin. J. Inorg. Chem. 2012, 10, 2103–2108. [Google Scholar]
- Li, Y.Z.; Wang, B.J.; Sui, X.F.; Xie, R.Y.; Xu, H.; Zhang, L.P.; Zhong, Y.; Mao, Z.P. Durable flame retardant and antibacterial finishing on cotton fabrics with cyclotriphosphazene/polydopamine/silver nanoparticles hybrid coatings. Appl. Surf. Sci. 2018, 435, 1337–1343. [Google Scholar] [CrossRef]
- Naskar, A.; Lee, S.; Kim, K.S. Easy one-pot low-temperature synthesized Ag-ZnO nanoparticles and their activity against clinical isolates of methicillin-resistant staphylococcus aureus. Front. Bioeng. Biotech. 2020, 8, 216–228. [Google Scholar] [CrossRef] [PubMed]
- Liu, J.; Wu, Z.H.; He, Q.G.; Tian, Q.Y.; Wu, W.; Xiao, X.H.; Jiang, C.Z. Catalytic application and mechanism studies of argentic chloride coupled Ag/Au hollow heterostructures: Considering the interface between Ag/Au bimetals. Nanoscale Res. Lett. 2020, 14, 35–44. [Google Scholar] [CrossRef] [PubMed]
- Kong, H.; Jang, J. One-step fabrication of silver nanoparticle embedded polymer nanofibers by radical-mediated dispersion polymerization. Chem. Commun. 2006, 28, 3010–3012. [Google Scholar] [CrossRef] [PubMed]
- Zhao, J.; An, Q.F.; Li, X.Q.; Xu, W. Film morphology of supramolecule CPES/ASO and its performance on cotton substrates. Fibers Polym. 2014, 15, 2112–2117. [Google Scholar] [CrossRef]
- Zhang, C.Z.; Su, J.J.; Zhu, X.H.X.; Xiong, J.H.; Liu, X.L.; Li, D.X.; Chen, Y.M.; Li, Y.H. The removal of heavy metal ions from aqueous solutions by amine functionalized cellulose pretreated with microwave-H2O2. RSC Adv. 2017, 7, 34182–34191. [Google Scholar] [CrossRef]
- Zhang, D.S.; Liao, Y.F.; Lin, H.; Chen, Y.Y. Size controlled synthesis of silver nanoparticles and their application to antibacterial finishing of cotton fabrics. J. Text. Res. 2013, 34, 87–93. [Google Scholar]
- Zhang, D.S.; Chen, L.; Zang, C.F.; Chen, Y.Y.; Lin, H. Antibacterial cotton fabric grafted with silver nanoparticles and its excellent laundering durability. Carbohydr. Polym. 2013, 92, 2088–2094. [Google Scholar] [CrossRef]
- Dong, Z.L.; Dong, B.H. Color Measurement and Computer Color Matching; China Textile Press: Beijing, China, 2007; Volume 9, pp. 120–125. [Google Scholar]
- Guo, R.J.; Wen, J.; Gao, Y.; Li, T.Y.; Yan, H.; Wang, H.F.; Niu, B.L.; Jiang, K.Y. Effect of the adhesion of Ag coatings on the effectiveness and durability of antibacterial properties. J. Mater. Sci. 2018, 53, 1939–1948. [Google Scholar] [CrossRef]
- Cheon, J.Y.; Kim, S.J.; Rhee, Y.H.; Kwon, O.H.; Park, W.H. Shape-dependent antimicrobial activities of silver nanoparticles. Int. J. Nanomed. 2019, 14, 2773–2780. [Google Scholar] [CrossRef]
- Acharya, D.; Pandey, P.; Mohanta, B. A comparative study on the antibacterial activity of different shaped silver nanoparticles. Chem. Pap. 2021, 75, 4907–4915. [Google Scholar] [CrossRef]
- Lu, L.; Zheng, L.P.; Zhao, P.F.; Wang, J.W. Preparation and antifungal activity of Ag-SiO2 core-shell nanoparticles. Chin. J. Bioproc. Eng. 2014, 2, 51–55. [Google Scholar]
- Morones, J.R.; Elechiguerra, J.L.; Camacho, A.; Holt, K.; Kouri, J.B.; Ramírez, J.T.; Yacaman, M.J.; Morones, J.R.; Elechiguerra, J.L.; Camacho, A.; et al. The bactericidal effect of silver nanoparticles. Nanotechnology 2005, 16, 2346–2353. [Google Scholar] [CrossRef]
- Mirjalili, M.; Yaghmaei, N.J. Antibacterial properties of nano silver finish cellulose fabric. Nanostruct. Chem. 2013, 3, 43. [Google Scholar] [CrossRef]
- Cai, Z.S. Chemistry and Physics of Fibers; China Textile Press: Beijing, China, 2009; Volume 3, pp. 175–182. [Google Scholar]
- Bai, B.; Zhou, W.H.; Ding, Y.F.; Xu, A.Z.; Wang, Y.J.; Ding, W.J. Analysis method of cellulose pyrolysis dynamics. Biomass Chem. Eng. 2017, 51, 8–16. [Google Scholar] [CrossRef]

| Washing Times | O-C | PP-C | PPA-C |
|---|---|---|---|
| 1 | 18 | 37 | 27 |
| 10 | 18 | 35 | 24 |
| 20 | 18 | 31 | 21 |
| Fabrics | T (mm) | W (mm) | ||
|---|---|---|---|---|
| E.coli | S.aureus | E.coli | S.aureus | |
| O-C | 0 | 0 | 0 | 0 |
| PPA-C | 35.56 | 33.64 | 5.28 | 4.32 |
| PPA-C-10 | 34.39 | 32.75 | 4.69 | 3.87 |
| Fabrics | Parameters | Heating Rates (°C/min) | |||
|---|---|---|---|---|---|
| 5 | 10 | 15 | 20 | ||
| O-C | Ti | 234 | 258 | 258 | 258 |
| Tmax | 320 | 329 | 334 | 340 | |
| Ta0 | 340 | 350 | 350 | 350 | |
| CR (%) | 2.19 | 4.26 | 3.37 | 3.01 | |
| PP-C | Ti | 190 | 190 | 190 | 190 |
| Tmax | 258 | 265 | 269 | 273 | |
| Ta | 270 | 274 | 278 | 280 | |
| CR (%) | 14.22 | 21.36 | 23.94 | 26.84 | |
| PPA-C | Ti | 220 | 220 | 220 | 220 |
| Tmax | 286 | 291 | 294 | 297 | |
| Ta1 | 299 | 306 | 306 | 306 | |
| CR (%) | 13.42 | 18.66 | 20.49 | 18.79 | |
Publisher’s Note: MDPI stays neutral with regard to jurisdictional claims in published maps and institutional affiliations. |
© 2022 by the authors. Licensee MDPI, Basel, Switzerland. This article is an open access article distributed under the terms and conditions of the Creative Commons Attribution (CC BY) license (https://creativecommons.org/licenses/by/4.0/).
Share and Cite
Zhou, Q.; Chen, J.; Lu, Z.; Tian, Q.; Shao, J. In Situ Synthesis of Silver Nanoparticles on Flame-Retardant Cotton Textiles Treated with Biological Phytic Acid and Antibacterial Activity. Materials 2022, 15, 2537. https://doi.org/10.3390/ma15072537
Zhou Q, Chen J, Lu Z, Tian Q, Shao J. In Situ Synthesis of Silver Nanoparticles on Flame-Retardant Cotton Textiles Treated with Biological Phytic Acid and Antibacterial Activity. Materials. 2022; 15(7):2537. https://doi.org/10.3390/ma15072537
Chicago/Turabian StyleZhou, Qingqing, Jiayi Chen, Zhenqian Lu, Qiang Tian, and Jianzhong Shao. 2022. "In Situ Synthesis of Silver Nanoparticles on Flame-Retardant Cotton Textiles Treated with Biological Phytic Acid and Antibacterial Activity" Materials 15, no. 7: 2537. https://doi.org/10.3390/ma15072537
APA StyleZhou, Q., Chen, J., Lu, Z., Tian, Q., & Shao, J. (2022). In Situ Synthesis of Silver Nanoparticles on Flame-Retardant Cotton Textiles Treated with Biological Phytic Acid and Antibacterial Activity. Materials, 15(7), 2537. https://doi.org/10.3390/ma15072537





